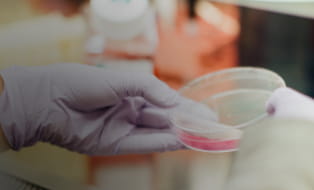

Clinical Trial Representation
Clinical research contributes to scientific knowledge for treatment options that may potentially benefit patients, physicians, and the broader research community in the future. Equitable access to clinical trials is integral to achieving health equity. Amgen is dedicated to the development of new drugs based on clinical trials, conducted without bias, and with representation of all patients who are afflicted with the disease we are seeking to treat.
In November 2020, Amgen, along with other members of the Pharmaceutical Research and Manufacturers of America (PhRMA), launched industry-wide principles on clinical trial representation with the goal of addressing the systemic issues that deter people of different races, sexes/genders, socioeconomic circumstances, and other system-level, individual-level, and interpersonal-level barriers from participating in clinical trials. Read more about these principles here.
Achieving representation in clinical trials is critical work that is the responsibility of all of us at Amgen. Founded in 2020, RISE (Representation in ClInical ReSEarch) is a team at Amgen that is dedicated to drive change by addressing the systemic issues that deter people from participating in research. The extraordinary response from colleagues across the company demonstrates the urgency and our shared commitment to addressing the issue head-on.
Why representation in clinical trials matters

Volunteer participants make a vital contribution to research and generate valuable information.

When some groups are underrepresented there is a risk of collecting insufficient data to assess effectiveness or safety in those populations.

Racial and/or ethnic background in combination with other interdependent factors can contribute to differences in drug exposure or response.

Equitable access to clinical trials is integral to achieving health equity.
Our Goals
RISE is working to exceed industry standards for clinical trial representation and to help Amgen develop new medicines studied in participants who better reflect the populations impacted by certain disease or conditions.

Evolve the way we design and run clinical trials, focusing on people who have been historically excluded from clinical research.

Partner with clinical trial investigators who are representative of the participants they are aiming to recruit.

Bring the research directly to the communities where people live and work.

Change how researchers communicate with patients, caregivers, and providers.

Enhance precision medicine awareness and improve genetic diversity in translational science.

Collaborate with national and community organizations.
Clinical trials have lacked representation for decades
Nearly 40% of Americans belong to a racial or ethnic minority, but individuals who participate in clinical trials for new drugs skew heavily White—in some cases, 80 to 90%.

Black/African Americans make up over 13% of the U.S. population, but only 7% of clinical trial participants.1,2

Hispanics/Latinos represent over 18% of the U.S. population, but only 11% of clinical trial participants.1,3

Asian Americans make up 6% of the U.S. population, but make up 1.7% of participants for drugs for which at least 70% of trials were conducted in the U.S.4
Hear from real patients to learn about their experience enrolling in Clinical Trials.
Our Work
African American Heart Study
On average, African Americans have higher Lp(a) levels than non-Hispanic whites. But most studies of Lp(a) and cardiovascular disease have been done in European populations. To understand the association of high Lp(a) levels with cardiovascular disease in African Americans, Amgen is sponsoring the African American Heart Study.
In partnership with the Association of Black Cardiologists (ABC) and Morehouse School of Medicine in Atlanta, the study aims to recruit 5,000 African Americans—2,500 with atherosclerotic cardiovascular disease (ASCVD), a condition that causes arteries to narrow, blocking blood flow to the heart and brain which can lead to heart attack or stroke, and 2,500 without ASCVD.
The study has the potential to help scientists better understand ASCVD and other diseases that disproportionately affect African Americans. The learnings from the African American Heart Study may also inform future clinical trials and drug development.
Robert A. Winn Excellence Awards

The Robert A. Winn Excellence in Clinical Trials Award Program was established to prepare early-career physician-researchers and medical students to implement high-impact studies that engage underrepresented populations. Amgen has pledged a total of $8 million dollars to the program for a four-year period. With the help of this donation, the program will be able to contact more doctors and medical students, furthering its mission to ensure new therapies are safe and effective for all who will use them—and that the latest medical advances reach those who need them most.